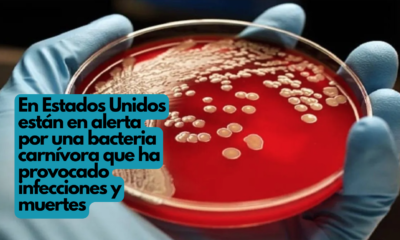
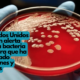

En Estados Unidos están en alerta por una bacteria carnívora que ha provocado infecciones y muertes, lo que ha despertado preocupación en otros países del mundo....



El Gobierno Municipal de Chihuahua, pone a disposición el Instituto Municipal de Prevención y Atención a la Salud (IMPAS), cuyo compromiso es enriquecer y consolidar el...



Bajo el compromiso del alcalde Marco Bonilla, de acercar servicios de salud a todas las familias de Chihuahua Capital, el Gobierno Municipal a través del Instituto...



El Consejo Nacional Agropecuario (CNA) aseguró que los maíces transgénicos se han utilizado por más de 25 años en el mundo y no existe evidencia científica...



La Organización Mundial de la Salud (OMS) ha agregado un nuevo linaje de COVID-19, EG.5.1, también conocida como Eris, a la lista de “variantes de interés”,...



El Consejo Nacional de Evaluación de la Política de Desarrollo Social (Coneval) informó este jueves que más de 30 millones de personas en México dejaron de...



Los casos de COVID-19 experimentaron un aumento del 80 por ciento en las últimas cuatro semanas (del 10 de julio al 6 de agosto), debido principalmente...



Terminar con el sistema del Seguro Popular en México, que durante dos décadas dio atención médica a la población no asegurada, era necesario, pero el error...



En el mes pasado, solo un 25 por ciento de los países en el mundo comunicaron muertes por COVID-19, y un porcentaje aún menor, del 11...



Recientemente en redes sociales, sobre todo el TikTok, se ha hablado mucho sobre el uso de un medicamento que se llama Ozempic. Su gracia, supuestamente, es...